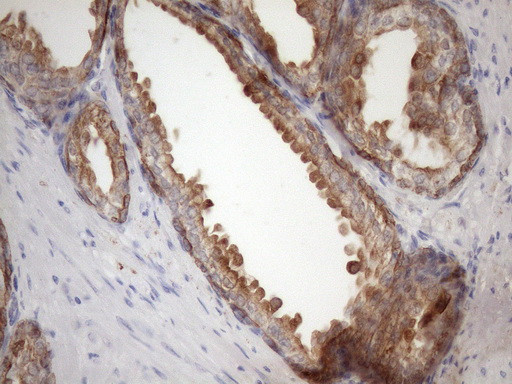
EGLN2 Antibody in Immunohistochemistry (Paraffin) (IHC (P))

Search
OriGene
EGLN2 Monoclonal Antibody (OTI7H3), TrueMAB™
{{$productOrderCtrl.translations['antibody.pdp.commerceCard.promotion.promotions']}}
{{$productOrderCtrl.translations['antibody.pdp.commerceCard.promotion.viewpromo']}}
{{$productOrderCtrl.translations['antibody.pdp.commerceCard.promotion.promocode']}}: {{promo.promoCode}} {{promo.promoTitle}} {{promo.promoDescription}}. {{$productOrderCtrl.translations['antibody.pdp.commerceCard.promotion.learnmore']}}
产品信息
TA808584
种属反应
宿主/亚型
分类
类型
克隆号
抗原
偶联物
形式
浓度
纯化类型
保存液
内含物
保存条件
运输条件
靶标信息
Prolyl hydroxylase domain proteins HIF PHD1, HIF PHD2 and HIF PHD3 (known as PHD1, PHD2 and PHD3 in rodents, respectively) can hydroxylate HIF-alpha subunits. Hypoxia-inducible factor (HIF) is a transcriptional regulator important in several aspects of oxygen homeostasis. The prolyl hydroxylases catalyze the posttranslational formation of 4-hydroxyproline in HIF-alpha proteins. HIF PHD1, which is widely expressed, with highest levels of expression in testis, functions as a cellular oxygen sensor and is important in cell growth regulation. HIF PHD1 can localize to the nucleus or the cytoplasm and is also detected in hormone responsive tissues, such as normal and cancerous mammary, ovarian and prostate epithelium. HIF PHD1 is encoded by EGLN2, which maps to chromosome 19q13. 3.
仅用于科研。不用于诊断过程。未经明确授权不得转售。
篇参考文献 (0)
生物信息学
蛋白别名: Egl nine homolog 2; egl-9 family hypoxia-inducible factor 2; EIT-6; Estrogen-induced tag 6; HIF-P4H 1; HIF-PH1; HIF-prolyl hydroxylase 1; HPH-3; Hypoxia-inducible factor prolyl hydroxylase 1; P4H1; PHD1; Prolyl hydroxylase domain-containing protein 1; Prolyl hydroxylase EGLN2
基因别名: EGLN2; EIT6; HIF-PH1; HIFPH1; HPH-1; HPH-3; PHD1
UniProt ID: (Human) Q8WWY4
Entrez Gene ID: (Human) 112398